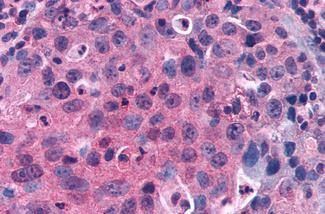
GPRC5C Antibody in Immunohistochemistry (Paraffin) (IHC (P))

Search
Invitrogen
GPRC5C Polyclonal Antibody
{{$productOrderCtrl.translations['antibody.pdp.commerceCard.promotion.promotions']}}
{{$productOrderCtrl.translations['antibody.pdp.commerceCard.promotion.viewpromo']}}
{{$productOrderCtrl.translations['antibody.pdp.commerceCard.promotion.promocode']}}: {{promo.promoCode}} {{promo.promoTitle}} {{promo.promoDescription}}. {{$productOrderCtrl.translations['antibody.pdp.commerceCard.promotion.learnmore']}}
产品信息
PA1-32549
宿主/亚型
分类
类型
抗原
偶联物
形式
浓度
规格
保存条件
运输条件
RRID
产品详细信息
PA1-32549 detects GPCR GPRC5C from human samples.
靶标信息
This polyclonal antibody was raised in Rabbit against GPRC5C. This antibody is unconjugated. This antibody is useful for testing in the following assays: IHC-P. The specificity of this antibody has been described as follows: Human GPRC5C. BLAST analysis of the peptide immunogen showed no homology with other human proteins.
仅用于科研。不用于诊断过程。未经明确授权不得转售。